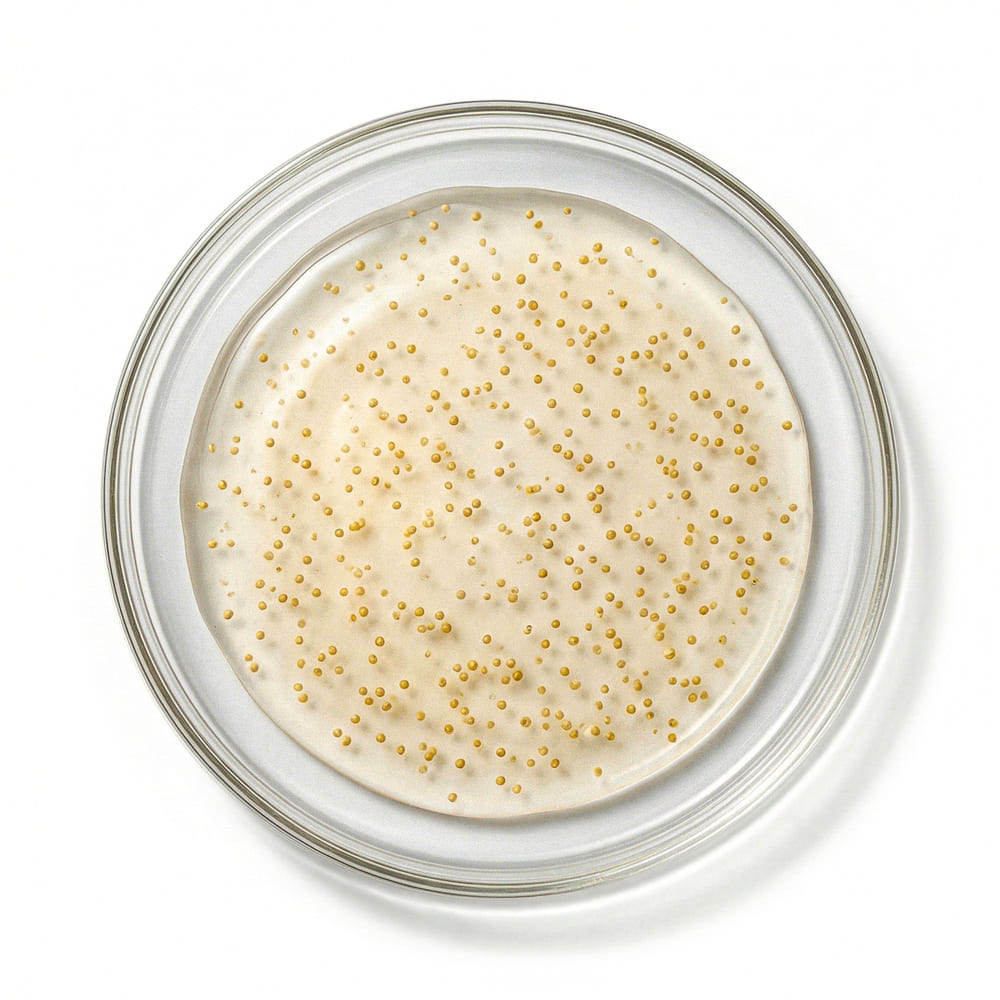

Geïrriteerde huid? Onze AfterCare Lotion kalmeert direct, en helpt de huidbarrière te herstellen. Unieke formula van ons Ceramiden Complex® en Centella Asiatica.
-
 24 uur lang irritatievrij
24 uur lang irritatievrij -
 Gevoelige huid
Gevoelige huid -
 Ceramides®, Centella & Zink
Ceramides®, Centella & Zink -
90% natuurlijke ingrediënten
Gratis Cadeaus
Alle ingrediënten
Waarom abonneren?
Dankzij AluBlend™, onze gepatenteerde mix van zuivere aluminiumzouten, siaalzuur, hexapeptide-8 en natuurlijke extracten, houdt het zweet onder controle. Sterker nog, 92% van de gebruikers zag een aanzienlijke vermindering van transpiratie in ons consumentenonderzoek.*
- Nooit meer zonder - Blijf droog dankzij de automatische navulling.
- Bespaar geld - Profiteer van tot wel 40% korting en gratis verzending.
- Betere resultaten - Consistent gebruik is de sleutel tot optimale bescherming.
- Geen gedoe - Je hoeft er niet aan te denken om opnieuw te bestellen. Wij regelen het voor je.
- Flexibel en aanpasbaar -Pas aan, pauzeer of annuleer wanneer je wilt.
- Exclusieve voordelen - Vroege toegang tot nieuwe producten en speciale beloningen.

Geld Terug Garantie
Ben je binnen 3 maanden niet tevreden? Dan krijg je je geld volledig terug – zonder addertjes onder het gras, zonder kleine lettertjes en zonder dat je het product hoeft terug te sturen. Zo simpel is het. Probeer Calmdry nu, 100% risicovrij!


Unieke formule
-
Hoe werkt het?
-
Hoe gebruik je het?
-
Geschikt voor de gevoelige huid?
-
Hoe werkt het?
-
Hoe gebruik je het?
-
Geschikt voor de gevoelige huid?
Bewezen voordelen,
Bewezen resultaten
*Gebaseerd op een consumentenonderzoek onder 36 personen, die gedurende 60 dagen 23 keer onze AfterCare Lotion hebben gebruikt.
Wat kun je verwachten?
Populaire producten
Veelgestelde vragen
Makkelijk annuleren
Makkelijk annuleren
Moet je een pauze nemen van je abonnement?
Voor meer details over ons abonnementsannuleringsbeleid, of hoe ons klantaccount werkt, bekijk onze FAQ hier.